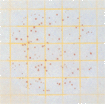

檢測認證人脈交流通訊錄
檢測認證人脈交流通訊錄
- 序號 產(chǎn)品編號 產(chǎn)品名稱 包裝規(guī)格
1 6406 3M菌落總數(shù)測試片 50片/袋
2 6416 3M大腸菌群測試片 25片/袋
3 6415 3M高靈敏度大腸菌群測試片 25片/袋
4 6412 3M快速大腸菌群測試片 25片/袋
5 6414 3M大腸菌群/大腸桿菌測試片 25片/袋
6 6491 3M 金黃色葡萄球菌測試片 25片/袋
7 6493 3M金黃色葡萄球菌確認反應(yīng)片 20片/袋
8 6417 3M霉菌和酵母菌測試片 50片/袋
9 6421 3M腸桿菌科測試片 25片/袋
10 6448 3M環(huán)境李斯特菌測試片 25片/袋
色播五月综合网|
久久久久久久久久一区二区三区|
一区二区三区精|
日本精品人妻无码77777|
日本最新中文字幕|
91l九色lporny|
久久久精品一区二区涩爱|
中文字幕无码人妻少妇免费|
精品999在线|
图片区偷拍区小说区|
三上悠亚av一区二区三区|
天堂www中文在线资源|
日韩av.com|
b站大片免费直播|
久草视频在线观|
男人的天堂久久久|
91麻豆国产在线|
aa在线观看视频|
香蕉久久国产av一区二区|
欧美婷婷精品激情|
一级国产黄色片|
久久高清免费视频|
日本中文在线视频|
亚洲国产av一区二区|
www.99av.com|
成人黄色a级片|
最新黄色网址在线观看|
国产素人在线观看|
日本久久久久久久久久|
日韩精品视频免费看|
国产黄色小视频网站|
国产老妇伦国产熟女老妇视频|
日韩av综合在线观看|
最新版天堂资源在线|
日韩精品视频免费播放|
日韩中文字幕在线不卡|
午夜av免费观看|
国产小视频在线观看免费|
青青青在线免费观看|
亚洲男女视频在线观看|
午夜免费福利网站|
国产又粗又爽又黄的视频|
视频一区二区免费|
国产又色又爽又黄的|
欧美视频在线第一页|
欧美一级特黄高清视频|
青娱乐精品在线|
国产aⅴ激情无码久久久无码|
特级毛片www|
丰满爆乳一区二区三区|
wwwwxxxx国产|
国产偷拍一区二区|
欧美激情精品久久|
国产小视频免费|
内射中出日韩无国产剧情|
久草热在线观看|
久久久精品麻豆|
午夜精品一区二区三区视频|
日本黄色三级网站|
亚洲大尺度在线观看|
久久久精品麻豆|
中国老女人av|
污网站免费观看|
一区二区日韩视频|
国产一级做a爱免费视频|
成人免费看片'免费看|
亚洲一区二区观看|
欧美 日韩 国产 在线|
五月天综合激情|
中文字幕国内自拍|
黄色三级中文字幕|
妺妺窝人体色WWW精品|
午夜影院免费视频|
国产精品热久久|
性无码专区无码|
欧美成人黄色网址|
69sex久久精品国产麻豆|
免费成人深夜天涯网站|
天天射天天操天天干|
91亚洲欧美激情|
午夜毛片在线观看|
gogogo高清免费观看在线视频|
精品一二三四五区|
亚洲综合网在线|
色欲狠狠躁天天躁无码中文字幕|
日本少妇激三级做爰在线|
一女二男一黄一片|
五月婷婷丁香在线|
国产成人愉拍精品久久|
欧美日韩精品区别|
性欧美极品xxxx欧美一区二区|
亚洲精品国产suv一区88|
影音先锋男人看片资源|
日本xxx在线播放|
麻豆免费在线观看视频|
日本激情一区二区三区|
a在线观看免费|
在线视频精品免费|
国产伦精品一区二区三区视频网站|
日本精品一区在线|
亚洲一级免费观看|
久久九九国产视频|
国语对白做受xxxxx在线中国
|
久久精品视频1|
久久婷婷一区二区|
久久黄色小视频|
91aaa精品|
中文字幕国产高清|
日本精品一区在线|
亚洲黄色av片|
mm131亚洲精品|
97超碰成人在线|
天堂一区在线观看|
中文字幕丰满乱码|
福利视频999|
一级日本黄色片|
三级黄色片免费看|
国产无精乱码一区二区三区|
黄色在线观看免费|
国产对白videos麻豆高潮|
日本一区二区欧美|
丰满少妇xoxoxo视频|
精品国产xxx|
在线观看国产小视频|
一级久久久久久久|
性猛交富婆╳xxx乱大交天津|
国产av无码专区亚洲a∨毛片|
国产成人精品亚洲精品色欲|
www.国产麻豆|
国产精久久久久|
成人乱码一区二区三区av|
日本美女xxx|
少妇久久久久久被弄高潮|
国产精品久久久影院|
青青草精品视频在线|
久久精品午夜福利|
91aaa精品|
无码人妻av一区二区三区波多野|
中文字幕a级片|
亚洲av无码专区在线|
可以看的av网址|
韩国女同性做爰三级|
欧美激情图片小说|
可以在线看的av网站|
亚洲最大综合网|
日本亚洲欧美在线|
亚洲字幕av一区二区三区四区|
国产成人精品亚洲精品色欲|
无码国产精品一区二区高潮|
伊人网伊人影院|
大地资源第二页在线观看高清版|
免费国产a级片|
欧美日韩精品亚洲精品|
jizz国产在线观看|
高清毛片aaaaaaaaa片|
青青草视频播放|
在线观看视频黄色|
性生交免费视频|
午夜毛片在线观看|
开心激情综合网|
鲁丝一区二区三区|
日本人体一区二区|
欧美日韩在线观看成人
|
97免费公开视频|
成熟人妻av无码专区|
日本黄色片一级片|
亚洲无在线观看|
97人妻人人澡人人爽人人精品|
亚洲精品鲁一鲁一区二区三区|
a级片在线观看|
久久国产精品视频在线观看|
黄色在线观看免费|
www.国产麻豆|
黄色一级片一级片|
韩国日本在线视频|
嫩草影院一区二区三区|
国产高潮失禁喷水爽到抽搐
|
av电影中文字幕|
疯狂试爱三2浴室激情视频|
黑人粗进入欧美aaaaa|
亚洲精品91天天久久人人|
av影片在线播放|
在线观看污视频|
国产在线观看99|
凸凹人妻人人澡人人添|
成人羞羞国产免费图片|
亚洲女人在线观看|
蜜桃久久一区二区三区|
a级黄色免费视频|
免费涩涩18网站入口|
国产高清第一页|
欧美成人久久久免费播放|
天天干天天干天天干天天干天天干|
夜夜躁日日躁狠狠久久av|
国产三级视频网站|
免费无码av片在线观看|
一道本无吗一区|
夫妇交换中文字幕|
免费黄频在线观看|
深爱五月激情五月|
国产免费内射又粗又爽密桃视频|
免看一级a毛片一片成人不卡|
欧美一区,二区|
国产一区二区三区小说|
国产亚洲欧美日韩高清|
伊人网在线视频观看|
一区二区三区 日韩|
欧美自拍偷拍一区二区|
一二三四中文字幕|
少妇无套内谢久久久久|
伊人影院综合网|
久草免费新视频|
青青草视频播放|
99热这里只有精品在线播放|
黄色一级大片在线免费看国产|
成人免费在线网|
国产v在线观看|
久操手机在线视频|
这里只有久久精品视频|
日韩国产第一页|
日本一区二区免费电影|
嘿嘿视频在线观看|
日本亚洲色大成网站www久久|
丰满少妇高潮一区二区|
三级黄色片播放|
国产精品无码电影|
久久婷婷中文字幕|
久久av无码精品人妻系列试探|
国产5g成人5g天天爽|
初高中福利视频网站|
污污的网站18|
精品人妻一区二区三区日产|
极品粉嫩美女露脸啪啪|
熟女少妇一区二区三区|
日韩黄色a级片|
www.97视频|
6—12呦国产精品|
国产手机免费视频|
天天操天天干天天操|
91看片在线免费观看|
中文成人无字幕乱码精品区|
久草国产在线视频|
久久99久久99精品免费看小说|
台湾佬中文在线|
手机在线免费看毛片|
特一级黄色大片|
精品一区二区成人免费视频|
怡春院在线视频|
天堂…中文在线最新版在线|
不卡的日韩av|
激情五月开心婷婷|
亚洲欧美色图视频|
国产一级aa大片毛片|
免费看黄色的视频|
国产成人黄色网址|
亚洲精品国产熟女久久久|
国产成人无码精品亚洲|
91嫩草丨国产丨精品|
国产免费无遮挡|
91视频 -- 69xx|
蜜桃色一区二区三区|
麻豆亚洲av成人无码久久精品|
加勒比综合在线|
国产精品国产三级国产aⅴ|
久久99久久99精品|
又黄又爽又色的视频|
jizz国产免费|
欧美 日韩 国产 在线观看|
国产免费黄色网址|
亚洲综合伊人久久|
极品尤物一区二区|
一道本无吗一区|
中文字幕成人免费视频|
中文字幕人妻一区二区|
国产精品久久久久久久久久久久久久久久久
|
涩多多在线观看|
开心激情五月网|
色欲久久久天天天综合网|
激情黄色小视频|
波兰性xxxxx极品hd|
三级网站在线看|
www.偷拍.com|
美国av在线播放|
国产精品九九视频|
天天操天天操天天操天天|
超薄肉色丝袜足j调教99|
99re这里只有|
中文人妻熟女乱又乱精品|
日本午夜激情视频|
呻吟揉丰满对白91乃国产区|
国产成人毛毛毛片|
99视频在线观看视频|
日本免费a视频|
老司机免费视频|
又污又黄的网站|
久久亚洲成人av|
真人抽搐一进一出视频|
精品人妻一区二区三区麻豆91|
国产精品6666|
18禁男女爽爽爽午夜网站免费|
黄页网站在线看|
国产巨乳在线观看|
日韩欧美中文视频|
婷婷色中文字幕|
37p粉嫩大胆色噜噜噜|
国产情侣一区二区|
亚洲欧美手机在线|
青青青在线观看视频|
粉嫩av蜜桃av蜜臀av|
色综合视频在线|
久草热在线观看|
国产喷水theporn|
成人一对一视频|
91免费在线看片|
国产性猛交96|
天天操天天射天天|
亚洲天堂网在线观看视频|
日本老熟妇毛茸茸|
欧美黑人经典片免费观看|
中文字幕91视频|
亚洲美女高潮久久久|
91精品国自产|
最近中文字幕在线免费观看|
日本高清免费在线视频|
日韩精品 欧美|
人妻激情另类乱人伦人妻|
一级片黄色录像|
精品人妻一区二区三区四区不卡
|
国产精品久久中文字幕|
亚洲欧美另类日本|
精品人妻在线视频|
国产99对白在线播放|
无码人妻黑人中文字幕|
国产成人无码精品|
久操免费在线视频|
日本爱爱免费视频|
另类小说色综合|
欧美亚洲一二三区|
日日噜噜噜夜夜爽爽|
国产成人av一区二区三区不卡|
亚洲欧美自偷自拍|
日本r级电影在线观看
|
国产三级视频网站|
亚洲国产果冻传媒av在线观看|
男人天堂av网|
国产人妖在线播放|
精品人妻无码一区二区三区蜜桃一|
免费视频网站在线观看入口|
国产精品变态另类虐交|
免费成人黄色大片|
最近中文字幕一区二区|
日本高清久久久|
天天操天天爽天天射|
国产乱子夫妻xx黑人xyx真爽|
久久精品国产精品亚洲色婷婷|
国产在线观看欧美|
女人十八毛片嫩草av|
在线小视频你懂的|
av黄色免费网站|
91香蕉国产视频|
男人天堂资源网|
国产在视频线精品视频|
日韩av手机在线免费观看|
91导航在线观看|
国产精品无码一区二区三区免费|
国产精品免费无码|
一级在线观看视频|
亚洲小视频在线播放|
欧美日韩中文字幕在线播放
|
国产熟妇搡bbbb搡bbbb|
а√天堂资源在线|
中文字幕第3页|
欧美成人三级伦在线观看|
摸摸摸bbb毛毛毛片|
国产一二三四视频|
日本一级二级视频|
日日橹狠狠爱欧美超碰|
欧美一级黄色影院|
久久高清无码视频|
国产一级淫片a视频免费观看|
波多野结衣高清在线|
免费看黄色一级视频|
无码人妻一区二区三区在线|
91成人精品一区二区|
破处女黄色一级片|
www.亚洲视频.com|
色综合五月婷婷|
日本黄色片视频|
www.四虎在线观看|
国产乱淫av麻豆国产免费|
69xxx免费视频|
老熟妇高潮一区二区三区|
91大学生片黄在线观看|
嫩草av久久伊人妇女超级a|
91在线第一页|
国产亚洲欧美久久久久|
国产熟女一区二区丰满|
亚洲欧美日韩中文字幕在线观看|
真人bbbbbbbbb毛片|
91在线播放观看|
 檢測認證人脈交流通訊錄
檢測認證人脈交流通訊錄